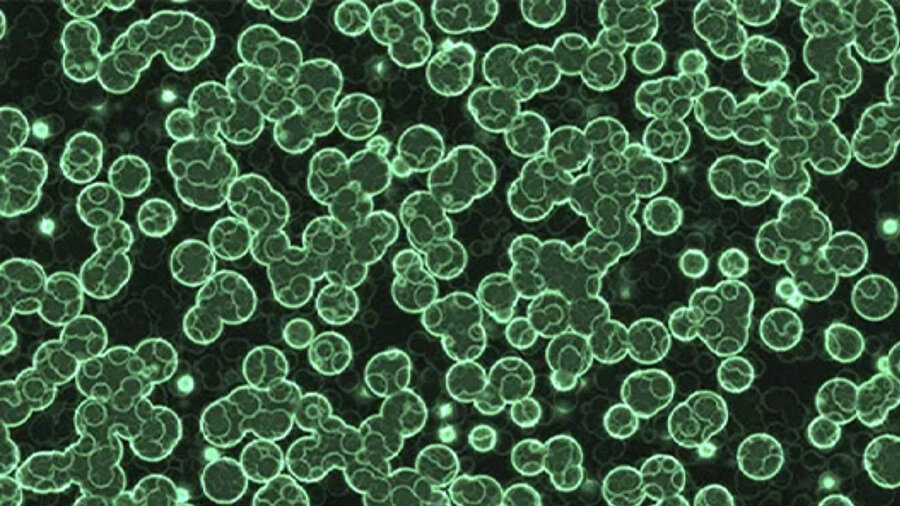

Yunuslarda Alzheimer benzeri bulgular mı görülüyor? Toksik algler ve iklim değişikliğinin etkileri

Florida’da karaya oturan yunuslarda, insanlardaki Alzheimer’a benzer beyin hasarları tespit edildi. Araştırmacılar, bu hasarların iklim değişikliğiyle artan toksik alg patlamalarına bağlı olduğunu belirtiyor. Yüksek nörotoksin seviyeleri, yunusların yön bulma ve hafıza yetilerini etkileyerek karaya oturmalarına yol açıyor. Bulgular, hem deniz canlıları hem de insan sağlığı için önemli uyarılar içeriyor.
Alzheimer ile bağlantılı beyin hasarı, yunusların yollarını kaybetmeleri ve karaya oturmalarının sebeplerinden biri olabilir mi? Bu olasılık, 2010-2019 yılları arasında Florida’daki Indian River Lagünü’nde karaya oturan 20 şişe burunlu yunus (Tursiops truncatus) üzerinde yapılan yeni bir çalışmada araştırıldı.
Araştırmacılar, yunuslarda görülen nörodejenerasyon belirtilerini, daha sıcak sularda artan toksik alg ve bakteri patlamaları yoluyla iklim değişikliğine bağladı.

Karaya oturan yunusların beyinlerinde yapılan analizler, insanlarda Alzheimer ile ilişkilendirilen gen ifadesi değişiklikleri ve kümelenmiş proteinler gibi hastalığa özgü hasarları ortaya koydu.
Özellikle yosun çiçeklenme dönemlerinde karaya vuran yunuslarda, diğer zamanlarda karaya oturan yunuslara kıyasla beyinlerinde 2.900 kat daha yüksek seviyede 2,4-diaminobütirik asit (2,4-DAB) adlı nörotoksin tespit edildi.
Bu durum, siyanobakteri kaynaklı toksinlerin zararlı etkilerinin bir göstergesi olup, yunusların yön bulma yetenekleri ve hafıza kaybı nedeniyle karaya vurma olaylarını açıklayabilir.

Miami Üniversitesi’nden toksikolog David Davis şu açıklamalarda bulundu:
- “Yunuslar, deniz ortamlarındaki toksik maddelere maruz kalmanın çevresel göstergeleri olarak kabul edildiği için, siyanobakteri çoğalmalarıyla bağlantılı insan sağlığı sorunları konusunda endişelerimiz var."
Siyanobakterilerin ürettiği toksinler hem hayvanlarda hem de insanlarda nöronlara zarar verebiliyor
Yunuslar yaşlandıkça genellikle Alzheimer’a çok benzeyen beyin sorunları geliştirir. Ayrıca, siyanobakterilerin ürettiği toksinlerin hem hayvanlarda hem de insanlarda nöronlara zarar verebildiği biliniyor, ancak insanlardaki nörodejeneratif hastalıklarla bağlantıları hâlâ araştırma aşamasında.
Riskler sadece yunuslarla sınırlı değil
Araştırma ekibi, bu sorunların yunuslarda zararlı alg çoğalmaları tarafından hızlandırılıp kötüleştirilebileceği önerisini ortaya koyuyor. Çalışma, hasara yol açan nörotoksinlerin yunus beyinlerindeki etkileri ve mevsimsel değişikliklere dair ayrıntıları da içeriyor.
Araştırmacılar, yayımladıkları makalede, “Bu iki yakın olayın beyin üzerindeki etkisini inceleme fırsatı bulduk,” diye belirtiyor.
Riskler sadece yunuslarla sınırlı değil; bu patlamalar birçok diğer deniz canlısına da zarar veriyor ve bu durum besin zinciri boyunca domino etkisi yaratarak nihayetinde insanlara kadar ulaşıyor.
Geçmişte yapılan araştırmalar, alg patlamalarını Alzheimer’ın temel belirtilerinden biri olan hafıza kaybına yol açabilen toksinlerle ilişkilendirmişti. Bu kimyasallar, yiyeceklerimize yeterince yüksek miktarlarda karıştığında ciddi bir sağlık sorunu oluşturabilir.
Siyanobakteriyel maruziyet giderek artan bir risk faktörü olarak karşımıza çıkıyor
Bu çalışma yunusları incelemekle birlikte, araştırmacılar beyindeki Alzheimer benzeri bazı temel değişimlerin insanlarda da benzer olduğunu vurguluyor. Henüz doğrudan bir bağlantı kanıtlanmamış olsa da, mevcut bulgular daha fazla araştırmayı gerektiriyor.
Aynı araştırma ekibinden bazı isimler daha önce siyanobakterilerin ve sikas ağaçlarında ürettikleri nörotoksinlerin çevrede kalıcı olduğunu ve besin zincirinde birikebildiğini göstermişti. Bu da potansiyel bir maruziyet yolu oluşturuyor. Bu toksinlere maruz kalmanın insanlarda bunama da dahil olmak üzere çeşitli nörodejeneratif hastalıklara yol açabileceği düşünülüyor.
Davis, “Alzheimer hastalığına yol açan birçok farklı neden olsa da, siyanobakteriyel maruziyet giderek artan bir risk faktörü olarak karşımıza çıkıyor,” diyor.
Araştırmanın sonuçları Communication Biology dergisinde yayımlandı.

